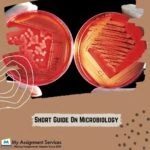

The study of microscopic organisms that can only be viewed with the aid of a microscope has become increasingly important in recent years. They are the planet\'s first living organism. They can survive high temperatures, acidity, and harsh environmental conditions at first. The majority of microbes are benign, but a few are hazardous. They have a symbiotic interaction with other creatures and can be found on every continent.
Some microbes live on the surface of humans\' skin (Staphylococcus) and intestine (E.coli produces vitamin K) as normal biota, preventing dangerous bacteria from entering. Probably, students ask for the Microbiology Homework Help USA to get their assignments done.
Students believe that the concepts are hard to understand and that they must read numerous books to gain a good comprehension, despite the fact that there is no required textbook for microbiology. Students must assess scenarios by evaluating past work references in incorporating and learning from them. Students must read on microbiology themes outside of class time.
Introduction of Microbiology
Microorganisms and their capabilities are critical to almost every process on Earth. Microorganisms are important because they are present in, on, and around us, and they have an impact on every part of our life. You can avail of Microbiology Homework Help USA to get your assignments done.
The study of all living creatures that are too small to be seen with the naked eye is known as microbiology. Microbes are bacteria, organisms, pathogens, fungus, prions, worms, and phytoplankton, which are all classified as bacteria. Carbon sequestration, photocatalytic degradation, environmental degradation, food poisoning, disease aetiology and control, and technology all rely on these bacteria. Microbes can be used in a variety of ways due to their versatility: manufacturing life-saving medications, Biofuel production, pollution cleanup, and food and beverage production/processing, for example.
Famous microbiologists, such as Jenner with his smallpox vaccine, Fleming with the penicillin, Marshall with the invention of the link between Helicobacter pylori infection with the discovery of the lilac virus, have all contributed some of the most significant findings that have shaped civilized life. Students can seek pharmacology homework help when they faced any issues with their assignments, online experts can assist them in completing their assignments.
Careers in Microbiology
A bachelor\'s degree is required for most positions in microbiology. A bachelor\'s degree in biology or microbiology can be obtained by someone concerned with microbiology. While a microbiology concentration will be more specialised to the preferences of someone who wishes to study microbiology, a biology student can obtain a similar level of competencies by taking upper-level microbiology courses. If one has interests in other disciplines of science or is simultaneously focusing on biology and another discipline, the biology major may be preferable. Both majoring in microbiology and biology. Students can probably seek pharmacology homework help to get their assignments done.
Microbiology is such a tough subject that students are required to seek Microbiology Homework Help USA from the experts to avail better grades.